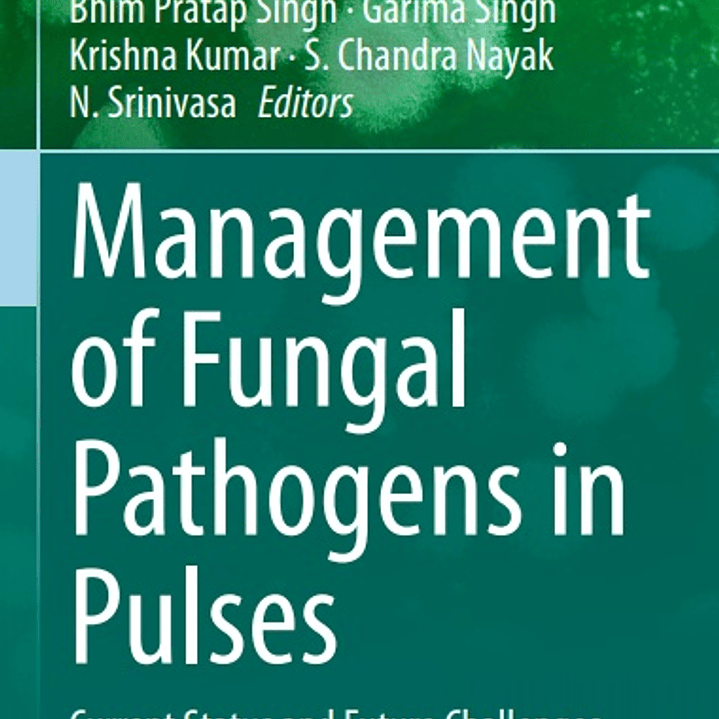

Management of Fungal Pathogens in Pulses: Current Status and Future Challenges
Description
(Fungal Biology) 1st ed. 2020 Edition
by Bhim Pratap Singh (Editor), Garima Singh (Editor), Krishna Kumar (Editor), S. Chandra Nayak (Editor), N. Srinivasa (Editor)
Pulses have played a major role in
human diet and are considered a rich source of proteins. But, the major
constraints in achieving the yield of pulses are the occurrences of various diseases and
pests. Hence, there is a need to understand major fungal pathogens and
their management strategies for sustainable agriculture. The major pulse
crops in India and other Asian countries are bengal gram, pigeon pea,
black gram, green gram, lentil and peas, which are attacked by several
pathogens that cause considerable crop damage. Bengal gram is affected
mainly by wilt (Fusarium oxysporum f. sp. ciceri), blight (Mycosphaerella pinodes) and rust (Uromyces ciceris-arietini). The main diseases of pigeon pea are wilt (Fusarium oxysporum) and Phytophtora stem blight (Phytophthora drechsleri f. sp. cajani). Powdery mildew (Erysiphe polygoni) and rust (Uromyces vicia-fabae)
are the most important diseases affecting the production of pea. This
volume offers details like symptoms, distribution, pathogens associated,
predisposing factors and epidemiology, sources of resistance and
holistic management of diseases with particular reference to those of
economic importance. Several minor diseases of lentil, green gram and of
black gram are discussed with their detailed and updated information.
This volume provides pooled information regarding the management of
major fungal phytopathogens affecting pulses.